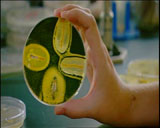

Dans le domaine de la santé, l'antibiotique est sans doute la plus grande découverte de tous les temps. Pour la premičre fois de son histoire, l'homme a pu neutraliser le microbe. Mais la surconsommation qui va suivre a un effet pervers : les bactéries s'adaptent, mutent génétiquement pour devenir immuno-résistantes. Et lorsque l'ętre humain prend conscience de ces mécanismes de résistance et de transfert de gčnes, il est déjŕ trop tard ! L'Aventure Antibiotique relate la guerre passionnante que l'homme et le microbe n'ont pas fini de se livrer. |



